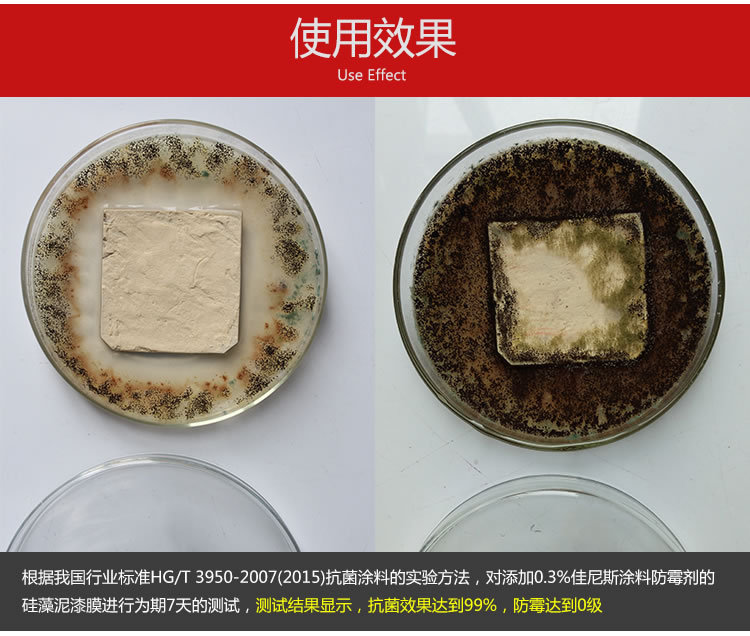

电话:
电话:
020-86532540
 手机:
手机:
18102206864
 邮箱:
邮箱:
yangtao@gnce.cn
 地址:
地址:
广东省广州市花都区狮岭镇新花路21号福野工业园3栋3楼
 微信:
微信:
扫一扫添加技术工程师微信









产品参数
外观:白色粉末 气味:无气味
表现密度:0.5g/mL 粒径:0.1-0.5mm
保质期:36个月 包装:25KG/桶
涂料防霉剂特点
1.耐候性好,防霉时效久:
硅藻泥防霉剂耐温性好,耐光照,自然条件下不分解不游离,优良的稳定性能保证了硅藻泥墙面5-10年内不发霉。
2.无毒无味环保安全:
不同于市面上常见的低毒中毒涂料防霉剂,该防霉剂属于实际无毒级别,施工后墙面无异味,儿童舔食墙面100%安全。
使用方法
如您对使用方法不清楚,请联系我司工程师:
本产品直接添加,使用量为0.3-05%先少量添加混合均匀后,再大量添加。
适用范围
油漆防霉剂AEM5700-T50是一种安全、有效、广谱的防霉剂,适用于添加到油漆及多种油性液体物质,起到防雪抗菌作用,
如油漆、涂料、矿物油等。